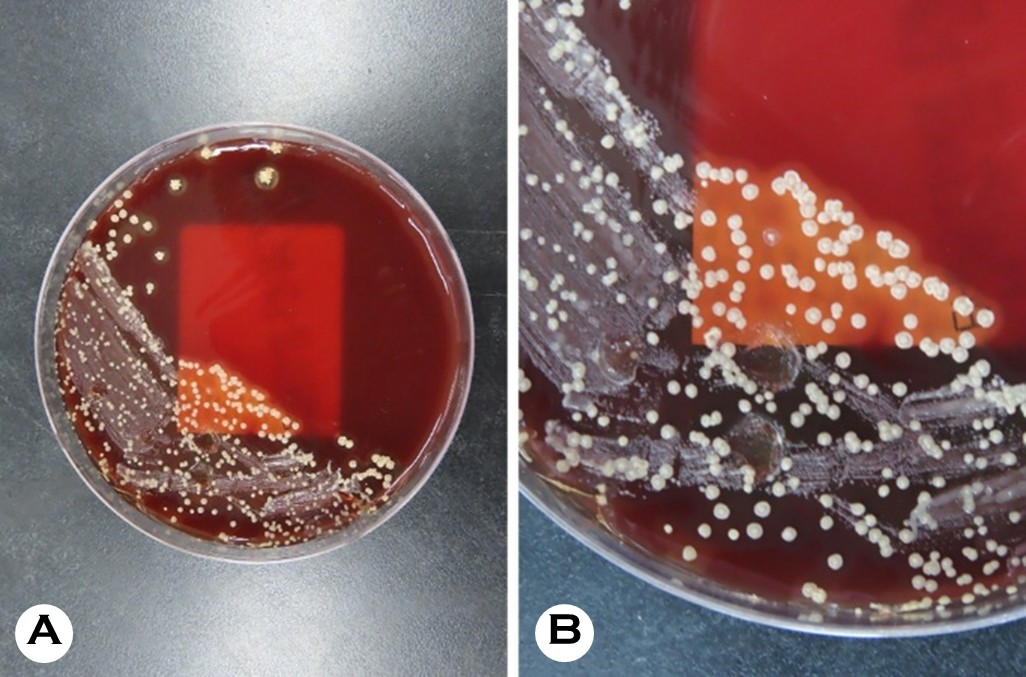

pISSN : 3058-423X eISSN: 3058-4302
Open Access, Peer-reviewed

pISSN : 3058-423X eISSN: 3058-4302
Open Access, Peer-reviewed
Jang-Hoon Yi,Kyung-Deok Park,Hyeong-Won Hong,Ki-Ho Kim,Jung-Ho Yoon
10.17966/JMI.2026.31.1.39 Epub 2026 March 31
Abstract
Human infection with Dermatophilus congolensis is an extremely rare zoonosis. This study aimed to report a case of a 30-year-old healthy urban man with refractory, linear, and crusted lesions on the face and left arm following a minor trauma. The diagnosis was confirmed via microbiological culture and matrix-assisted laser desorption/ ionization time-of-flight mass spectrometry (MALDI-TOF MS). Notably, the organism showed optimal growth only at a temperature of 37℃, whereas growth at a temperature of 30℃ was insignificant, suggesting a potential diagnostic pitfall. The patient was successfully treated with oral doxycycline. The findings of this study suggest the importance of considering D. congolensis in dermatitis unresponsive to empirical therapy and emphasize the diagnostic value of incubation at a temperature of 37℃ and MALDI-TOF MS.
Keywords
Dermatophilosis Dermatophilus congolensis MALDI-TOF MS Microbiological culture Zoonoses
Dermatophilus congolensis is a facultative anaerobic, Gram-positive actinomycete primarily responsible for exudative dermatitis, which is also referred to as dermatophilosis, in livestock1,2. Despite its prevalence, human infection with this veterinary pathogen is still considered a rare zoonosis3-5,9. The first human cases in the United States were reported in 1961 involving individuals exposed to an infected deer3,6,9,10. The clinical manifestations typically include pustules, exudative erythematous plaques, and crusts, which can often mimic different types of pyoderma or viral infection3,7,8. This study aimed to present a rare case of cutaneous D. congolensis infection in a healthy 30-year-old man with distinct linear crusted lesions and determine its clinical features and micro- biological identification to focus on this unusual entity in the differential diagnosis of treatment-refractory dermatitis.
This study investigated a 30-year-old healthy man who pre- sented with multiple pruritic, erythematous patches covered with thick yellowish crusts on his face and left arm. The lesions had been present for 1 month. The patient reported a history of a minor scratch on his left arm preceding the eruption. The lesions initially appeared at the site of trauma and subse- quently disseminated to his face. Despite 2 weeks of empirical treatment at a local clinic with oral antihistamines, antibiotics, topical antibiotics (mupirocin), and corticosteroids (predni- carbate and diflucortolone valerate), the lesions showed no improvement and continued to spread. Systemic symptoms, including fever and chills, were not observed. The patient was an office worker living in an urban area and denied recent travel or contact with livestock. He reported occasional con- tact with healthy dogs but showed no evidence of cutaneous infection.
The physical examination results revealed erythematous exudative patches with thick, adherent, yellowish-brown crusts on the face and left upper arm (Fig. 1 A, B). Notably, the lesions on the left arm showed a linear arrangement, suggesting autoinoculation via scratching (Fig. 1 C). A micro- biological examination was performed using a swab from an exudative lesion on the left arm. The sample was inocu- lated onto a 5% sheep blood agar plate. Initial incubation at a temperature of 30℃ with 5% CO2 for 24 hours yielded insignificant growth. However, subsequent incubation at a temperature of 37℃ with 2.5% CO2 for an additional 48 hours resulted in the profuse growth of colonies. The colonies showed several characteristic features, including a rough and wrinkled appearance, dry consistency, adherence to the agar substrate, and golden-yellow pigmentation with β-hemolysis (Fig. 2). The Gram staining results revealed Gram- positive organisms with significant pleomorphism. While a few branching filaments were observed, the smear was pre- dominantly composed of fragmented short filaments and coccoid cells arranged in distinctive cuboid packets (Fig. 3). For definitive identification, matrix-assisted laser desorption/ ionization time-of-flight mass spectrometry (MALDI-TOF MS) was performed using the VITEK MS system (bioMérieux, Marcy-l'Étoile, France) equipped with the IVD Database v3.2. The analysis identified the isolate as Dermatophilus congolensis with a 99.9% confidence level, suggesting a high-confidence identification (Fig. 4). Based on the clinical findings and microbiological confirmation, a diagnosis of cutaneous der- matophilosis was made. The patient was treated with 50 mg oral doxycycline twice daily for 2 weeks. At the 1-week follow-up visit, the exudative crusts and infiltrated plaques were almost completely resolved, indicating a dramatic response to the treatment. However, only residual indistinct erythema and post-inflammatory hyperpigmentation were observed (Fig. 1 D, E). No recurrence was observed during the 2-month follow-up period.

Dermatophilus congolensis is primarily a veterinary pathogen that causes exudative dermatitis1,2. Human infection with this pathogen is an exceptionally rare zoonosis, and reports of such cases in urban settings without occupational expo- sure are more limited3,5,12. Owing to its rarity and clinical resemblance to other common cutaneous infections, such as impetigo, contact dermatitis, or dermatophytosis, the diagnosis of human dermatophilosis is frequently delayed or missed1,4. The findings of this case report are significant as they describe a rare occurrence of D. congolensis infection in a healthy urban male and explain the critical microbiological features that facilitate an accurate diagnosis in the absence of histopathological confirmation. Although direct contact with infected animals, contaminated fomites, or vectors is the usual mode of transmission, the identification of the exact source is often challenging in urban settings3,8,11. Irrespective of the vector, penetration in the skin barrier is a prerequisite for infection. Factors such as minor trauma or moisture have been shown to compromise the stratum corneum, facilitating the invasion of motile, infective zoospores into the epidermis1,2,8. In the present case, a preceding minor scratch was likely the portal of entry, and the distinct linear distribution of the lesions suggests autoinoculation or a Koebner-like distribution along the line of trauma.
A definitive diagnosis of dermatophilosis relies on isolating the organism or identifying its characteristic morphological features in clinical specimens1,4,5. In the present case, micro- biological culture played a pivotal role. Nevertheless, our case encountered initial challenges, which have yielded significant insights for clinical laboratories. Although D. congolensis is generally known to optimally grow at a temperature of 37℃, routine skin cultures are often processed under protocols for superficial fungal infections, thereby using lower incubation temperatures2. Moreover, preliminary incubation at a temperature of 30℃ yielded insignificant growth, which could have been readily disregarded as negative or nonspecific. The characteristic rough, wrinkled, adherent, and golden-yellow colonies with β-hemolysis became prominent only after modifying the incubation condition to a temperature of 37℃ with 2.5% CO21,2,5,7-9. This observation emphasizes the fact that while the organism may survive at various temperatures, optimal isolation from human skin samples requires a strict adherence to higher incubation temperatures (37℃)1,2. Clini- cians and microbiologists should be aware of this requirement to avoid false-negative results, particularly when standard empirical treatments fail1.
Morphologically, D. congolensis is unique among the other types of actinomycetes because of its complex life cycle, which entails the maturation of filamentous hyphae into packets of motile zoospores through transverse and longitudinal septa- tions2. Histopathologic sections often reveal long, branching filaments with a pathognomonic "tram-track" appearance that invades the stratum corneum6,8. However, the Gram staining of our cultured colonies predominantly revealed fragmented short filaments and clusters of coccoid cells rather than lengthy hyphae. This discrepancy likely results from the organism reaching the zoospore stage and the inevitable fragmentation of delicate hyphae during the mechanical disruption of hard, adherent colonies. Crucially, the coccoid cells in our specimen were not randomly arranged, such as in staphylococci, but formed distinct cuboid packets, indicating the characteristic multidimensional septation of D. congolensis2. This specific arrangement serves as a key differentiating feature from other Gram-positive cocci in culture smears.
Furthermore, this case emphasizes the efficacy of MALDI-TOF MS as a rapid and reliable alternative to labor-intensive molecular methods5. The VITEK MS system was used to achieve a definitive diagnosis with 99.9% confidence, con- sistent with recent reports that support its utility for D. con- golensis5. Although 16S rRNA sequencing was not performed in the present study, the diagnosis was definitive based on the convergence of the high-confidence MALDI-TOF MS results (99.9%), pathognomonic microscopic features (cuboid pac- kets), characteristic colony morphology, and rapid clinical response. Consistent with the findings of recent validation studies, MALDI-TOF MS provides sufficient diagnostic accuracy when corroborated by concordant phenotypic and clinical findings. Consequently, when the clinical and culture findings are compatible, MALDI-TOF MS can be used as a definitive diagnostic tool, potentially sparing patients from undergoing invasive skin biopsies.
We propose a practical diagnostic workflow for clinicians encountering refractory cases. The presence of D. congolensis should be considered in the differential diagnosis of exudative crusted dermatitis unresponsive to conventional antibiotics and antifungal agents, even in urban patients without direct occupational exposure to livestock. Our findings suggest that incubation at a temperature of 37℃ is essential for optimal growth and colony expression. Crucially, when routine fungal cultures (typically incubated at a temperature of 25-30℃) yield negative results despite persistent clinical symptoms, clinicians should explicitly request bacterial culture with in- cubation at a temperature of 37℃.
Morphologically, the observation of distinct cuboid packets of coccoid cells in culture smears is a consistent diagnostic feature reflecting the organism's life cycle. Finally, MALDI-TOF MS serves as a powerful and accessible tool for definitive identification. The early recognition of these diagnostic pitfalls and an appropriate microbiological workup are essential to ensure rapid recovery with targeted antibiotic therapy.
References
1. Amor A, Enríquez A, Corcuera MT, Toro C, Herrero D, Baquero M. Is infection by Dermatophilus congolensis underdiagnosed? J Clin Microbiol 2011;49:449-451
Google Scholar
2. Gordon MA. The genus dermatophilus. J Bacteriol 1964; 88:509-522
Google Scholar
3. Aubin GG, Guillouzouic A, Chamoux C, Lepelletier D, Barbarot S, Corvec S. Two family members with skin infection due to Dermatophilus congolensis: Case report and literature review. Eur J Dermatol 2016;26:621-622
Google Scholar
4. Harman M, Sekin S, Akdeniz S. Human dermatophilosis mimicking ringworm. Br J Dermatol 2001;145:170-171
Google Scholar
5. Porras MI, Cañueto J, Ferreira L, García MI. Human dermatophilosis. First description in Spain and diagnosis by matrix-assisted laser desorption ionization time-of-flight mass spectrometry (MALDI-TOF). Enferm Infecc Microbiol Clin 2010;28:747-748
Google Scholar
6. Alejo-Cancho I, Bosch J, Vergara A, Mascaro JM, Marco F, Vila J. Dermatitis caused by Dermatophilus congolensis. Clin Microbiol Infect 2015;21:e73-74
Google Scholar
7. Burd EM, Juzych LA, Rudrik JT, Habib F. Pustular der- matitis caused by Dermatophilus congolensis. J Clin Microbiol 2007;45:1655-1658
Google Scholar
8. Towersey L, Martins Ede C, Londero AT, Hay RJ, Soares Filho PJ, Takiya CM, et al. Dermatophilus congolensis human infection. J Am Acad Dermatol 1993;29(2 Pt 2): 351-354
Google Scholar
9. Kaminski GW, Suter II. Human infection with Dermato- philus congolensis. Med J Aust 1976;1:443-447
Google Scholar
10. Salkin IF, Stone WB, Gordon MA. Dermatophilus con- golensis infections in wildlife in New York State. J Clin Microbiol 1981;14:604-606
Google Scholar
11. Pal M. Prevalence in India of Dermatophilus congolensis infection in clinical specimens from animals and humans. Rev Sci Tech 1995;14:857-863
Google Scholar
12. Zaria LT. Dermatophilus congolensis infection (Dermato- philosis) in animals and man! An update. Comp Immunol Microbiol Infect Dis 1993;16:179-222
Google Scholar
Congratulatory MessageClick here!